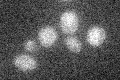
YOL029C

View description
Putative protein of unknown function; identified as interacting with Hsc82p and Hsp82p in high-throughput two-hybrid screens
Localization:
Intensity:
Fold change:
Significance:
-
C’ GFP library in SD

below threshold15.91 -
N' NOP1pr-GFP in SD

cytosol64.6218 -
N' TEF2pr-mCherry in SD

cytosol72.9338 -
N' NATIVEpr-GFP in SD

below threshold20.8984 -
N' TEF2pr-VC and Cyto-VN in SD

cytosol38.1757 -
C’ GFP library in SD+DTT

cytosol14.810.92No -
C’ GFP library in SD+H2O2

cytosol17.571.1No -
C’ GFP library in Starvation Media
cytosol16.671.04No -
C’ GFP library on the background of Pup2-DaMP

below threshold -
C’ GFP library on the background of CCT mutant

below threshold16.47851.03457No
